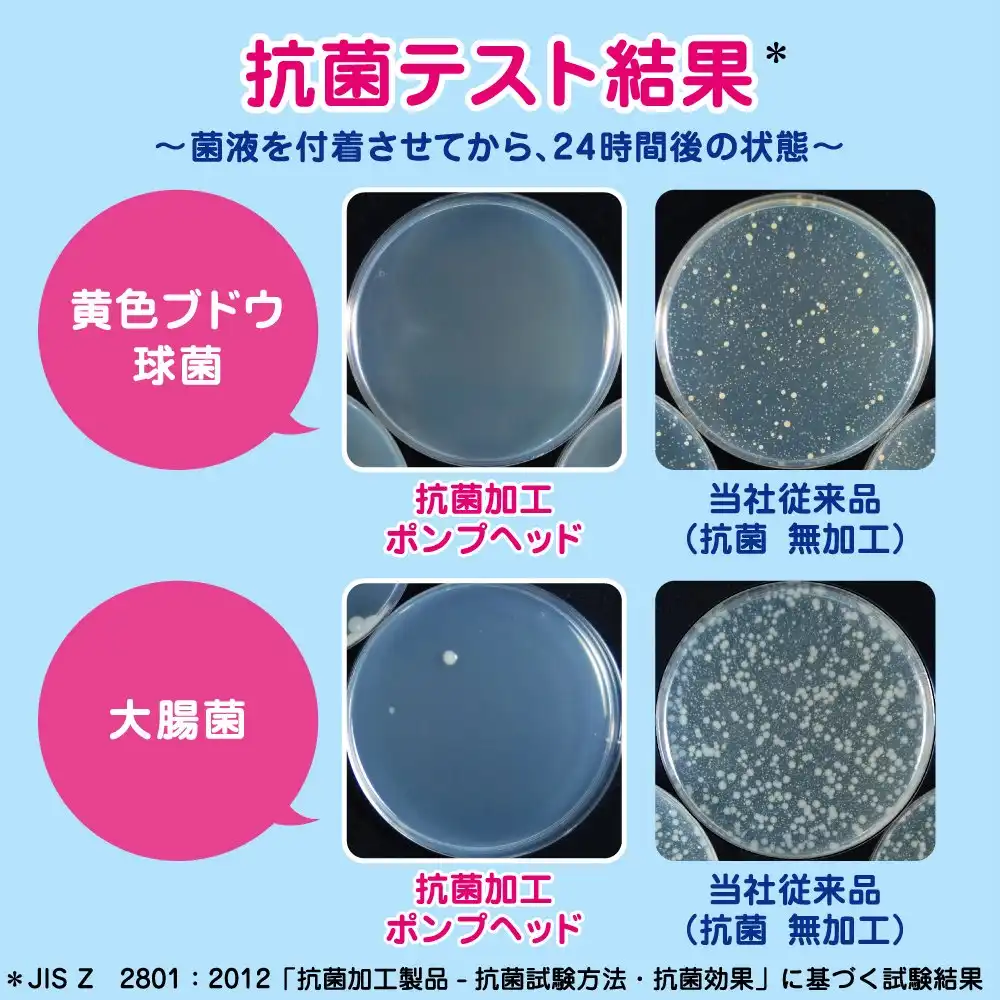

Size: 212.34 KB
Res: 1667x2560
Fmt: JPEG
Ch: 3 (R, G, B)
Depth: 8-bit

Size: 25.08 KB
Res: 781x1200
Fmt: WEBP
Ch: 3 (R, G, B)
Depth: 8-bit
(-88.2%)

Size: 363.56 KB
Res: 1667x2560
Fmt: JPEG
Ch: 3 (R, G, B)
Depth: 8-bit

Size: 52.00 KB
Res: 781x1200
Fmt: WEBP
Ch: 3 (R, G, B)
Depth: 8-bit
(-85.7%)

Size: 178.16 KB
Res: 1000x1000
Fmt: JPEG
Ch: 3 (R, G, B)
Depth: 8-bit
Size: 64.42 KB
Res: 1000x1000
Fmt: WEBP
Ch: 3 (R, G, B)
Depth: 8-bit
(-63.8%)